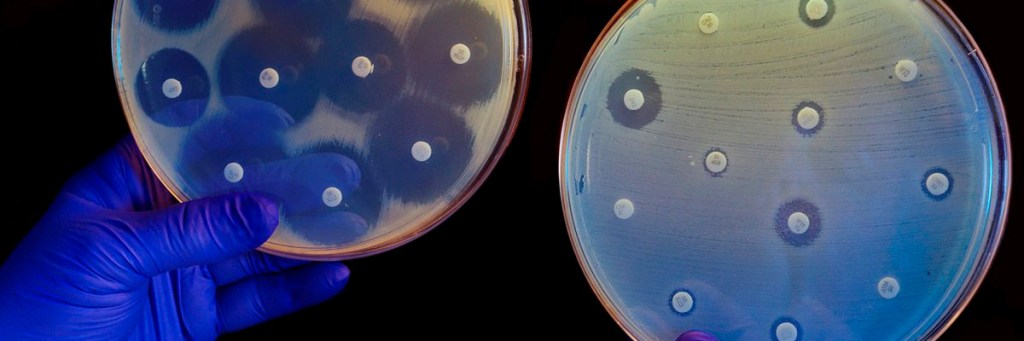

/Fuente: Federación Bioquímica de la Provincia de Buenos Aires/
Según un estudio publicado en ‘The Lancet’, la resistencia a los antimicrobianos podría matar en el próximo cuarto de siglo en el mundo a más de 39 millones de personas de forma directa y a 169 millones indirectamente, por asociación con otras patologías. El efecto será especialmente dramático entre los mayores de 70 años.
Infecciones, cirugías y prácticas médicas ordinarias se han vuelto a convertir en casos de vida o muerte para muchas personas, como antes de 1928, cuando se descubrió la penicilina y nacieron los antibióticos. Estos han salvado la vida a millones de pacientes que antes fallecían por una simple neumonía bacteriana (en los años treinta mataba a casi el 40% de los enfermos) o de las secuelas de una común infección. Pero a lo largo de estos años, las bacterias han aprendido a defenderse y a resistir a los efectos de los antibióticos, hasta alzarse como una de las 10 principales amenazas de la humanidad, según la Organización Mundial de la Salud (OMS). Una proyección que publica este martes The Lancet a partir de una investigación realizada hace dos años, tras el análisis de 520 millones de datos, calcula que la resistencia a los antimicrobianos (RAM por sus siglas en inglés) podría matar en el próximo cuarto de siglo en el mundo a más de 39 millones de personas de forma directa y a 169 millones indirectamente (por asociación con otras patologías). El efecto será especialmente dramático entre los mayores de 70 años, para quienes la incidencia crecerá entre un 72% en países de renta alta y el 234% en el norte de África y Oriente Próximo.
“Estamos llegando a la era posantibiótica, cuando ya no tendremos recursos que funcionen”, según Luis Ostrosky, jefe de enfermedades infecciosas y epidemiología en UTHealth Houston (University of Texas Health Science Center), ajeno al estudio. “La medicina depende del uso de antibióticos para cosas tan rutinarias como cirugías, terapias o trasplantes y estamos en un tiempo de la historia muy peligroso porque la resistencia antimicrobiana aumenta. En la práctica médica cotidiana encontramos infecciones que no son tratables con los antibióticos que existen ahora y eso es gravísimo”, explica.
Esta era posantibiótica comenzó a dejar su letal evidencia hace 30 años. Desde entonces y hasta el comienzo de la década actual, más de un millón de personas (entre 1,06 y 1,14 millones) han muerto anualmente por la resistencia a los antimicrobianos, especialmente aquellas que superan los 70 años, una edad a partir de la cual los casos de decesos por esta causa han aumentado en un 80%, según el nuevo estudio del Proyecto de Investigación Mundial sobre la Resistencia a los Antimicrobianos (GRAM por sus siglas en inglés).
De seguir así, esta cantidad casi se duplicará hasta 2050 y se elevará, según la investigación, a 1,91 millones de muertes anuales directas por la resistencia a los antimicrobianos, a las que habría que sumar los fallecimientos en los que la RAM desempeña un papel indirecto. Incluyendo estos últimos casos, los decesos aumentarán en casi un 75%, entre 4,71 millones y 8,22 millones por año.
En aumento
“Estos hallazgos ponen de manifiesto que la resistencia a los antimicrobianos ha sido una importante amenaza para la salud mundial durante décadas y que va en aumento. Es vital comprender cómo las tendencias en las muertes por resistencia antimicrobiana han cambiado con el tiempo y cómo es probable que cambien en el futuro para tomar decisiones que ayuden a salvar vidas”, afirma Mohsen Naghavi, autor del estudio y líder del equipo de investigación sobre la RAM en el Instituto de Métricas de Salud (IHME) de la Universidad de Washington.
El estudio refleja una tendencia dispar: mientras que alerta de que los efectos de la RAM se cebarán con los mayores de 70 años hasta duplicar los casos (un 72% de muertes más en los países de ingresos altos y un 234% en el norte de África y Oriente Próximo), por el contrario, detecta una reducción de más del 50%, entre 1990 y 2021, de los fallecimientos por la misma causa entre los menores de cinco años (de 488.000 a 193.000 muertes directas y de 2,29 millones a 840.000 indirectas). Esta buena senda se puede mantener entre los más pequeños por las mejoras en la aplicación de medidas de prevención y control de infecciones.
“La disminución de las muertes por sepsis [respuesta extrema del sistema inmunitario a una infección que lesiona tejidos y órganos] y resistencia a los antimicrobianos entre los niños pequeños en las últimas tres décadas es un logro increíble. Sin embargo, los hallazgos muestran que, si bien las infecciones se han vuelto menos comunes en los niños pequeños, se han vuelto más difíciles de tratar cuando ocurren. Además, la amenaza de la resistencia a los antimicrobianos para las personas mayores no hará más que aumentar a medida que la población envejezca. Ahora es el momento de actuar para proteger a las personas de todo el mundo de la amenaza que representa la RAM”, afirma Kevin Ikuta, doctor de la Universidad de California en Los Ángeles (UCLA) y coautor del estudio.
Estrategias para disminuir infecciones graves
Sobre estas actuaciones que reclama Ikuta y que podrían evitar 92 millones de fallecimientos, Stein Emil Vollset, del Instituto Noruego de Salud Pública y profesor afiliado del IHME, detalla: “Para evitar que esto [el pronóstico] se convierta en una realidad mortal, necesitamos urgentemente nuevas estrategias para disminuir el riesgo de infecciones graves a través de vacunas, nuevos medicamentos, una mejor atención médica, un mejor acceso a los antibióticos existentes y orientación sobre cómo usarlos de la manera más efectiva.
La importancia de las medidas preventivas la avala el hecho de que la tendencia al alza sostenida de RAM disminuyó temporalmente en 2021 por el distanciamiento social y otras medidas de control de enfermedades implementadas durante la pandemia de covid.
Pero la gran esperanza es el hallazgo de nuevos antibióticos porque, según insiste Naghavi, “los medicamentos antimicrobianos son una de las piedras angulares de la atención sanitaria moderna y el aumento de la resistencia a ellos es un motivo importante de preocupación”.
Nuevos antibióticos
En esta lucha por encontrar nuevas moléculas con capacidad antibiótica lleva años luchando el español César de la Fuente, responsable de un laboratorio que lleva su nombre en la Universidad de Pensilvania y que ha hallado miles de compuestos en antepasados, como los neandertales, especies animales extintas, como el mamut, y hasta en nuestro propio sistema digestivo.
De la Fuente coincide con la ONU: “La resistencia a los antibióticos es una de las mayores amenazas existenciales para la humanidad”. Según este estudio – comenta en relación con la investigación de The Lancet, en la que no ha participado – esta crisis ya está asociada con millones de muertes cada año, y se estima que para el año 2050, las infecciones resistentes a los antibióticos podrían estar asociadas con 8,22 millones de muertes anualmente si no se toman medidas urgentes. Este alarmante pronóstico subraya la necesidad inmediata de descubrir y desarrollar nuevos antibióticos, ya que las bacterias están adquiriendo resistencia a los tratamientos actuales, poniendo en riesgo la salud global y exacerbando la crisis sanitaria”.
“En los últimos años, el uso de la inteligencia artificial [IA] ha permitido acelerar significativamente el proceso de descubrimiento de nuevos antibióticos, reduciendo los tiempos de años a tan solo horas. Estoy convencido de que la IA puede jugar un papel clave en la solución de este problema de salud mundial”, explica.
Los autores del pronóstico recién publicado reconocen algunas limitaciones en su estudio, como la falta de datos sobre algunos países de ingresos bajos y medianos, la limitada información previa al año 2000 o que algunos de los 520 millones de registros individuales utilizados para producir las estimaciones pueden contener errores o sesgos.
Los autores del pronóstico recién publicado reconocen algunas limitaciones en su estudio, como la falta de datos sobre algunos países de ingresos bajos y medianos, la limitada información previa al año 2000 o que algunos de los 520 millones de registros individuales utilizados para producir las estimaciones pueden contener errores o sesgos.